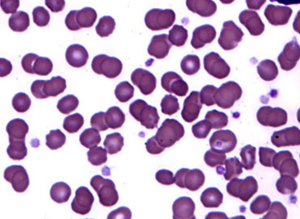

Despite the proven efficacy of biosimilars, both patients and health care providers often have some reluctance when switching from an originator drug to a biosimilar.

Despite the proven efficacy of biosimilars, both patients and health care providers often have some reluctance when switching from an originator drug to a biosimilar.

A study published in the American Journal of Preventive Cardiology found a systematic educational approach overcomes obstacles in prescribing guideline-directed antihyperglycemic medications.

Abemaciclib (Verzenio; Lilly) is the first addition to adjuvant endocrine therapy approved by the FDA in two decades.

Acalabrutinib (Calquence; AstraZeneca) provides efficacy while maintaining favorable tolerability for patients with chronic lymphocytic leukemia.

Isatuximab-irfc (Sarclisa; sanofi-aventis) provides patients with another option for treatment and significantly reduces the risk of disease progression or death.

A contraception toolkit helps them improve women's reproductive health.

Published: March 28th 2022 | Updated:
Published: March 25th 2022 | Updated: